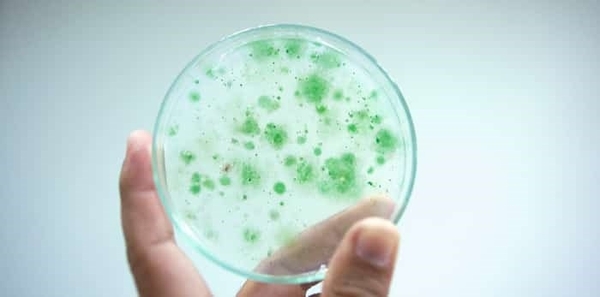

Vi sinh nở hoa (Bacteria bloom) hay chúng ta hay gọi bùng vi sinh, là một hiện tượng xảy ra khi số lượng vi khuẩn trong nước tăng đột biến trong môi trường nước. Hiện tượng này thường xuất hiện trong nhiều bể cá thủy sinh dẫn đến hiện tượng nước đục như nước vo gạo.
Hãy cùng Thủy Sinh 4U tham khảo thêm về hiện tượng này và một vài điều hiểu nhầm mà có thể bạn chưa biết.
Hiểu nhầm về vi sinh nở hoa
Trước đó khi thông tin chính xác về hiện tượng này chưa được làm rõ, người chơi cá cảnh thủy sinh thường gọi đây là hiện tượng “Chết vi sinh”, nhưng đây là thông tin sai lệch về hiện tượng nước đục có màu trắng như nước vo gạo này. Hiện tượng này có tên khoa học là (Bacteria bloom) hay tiếng việt gọi là (Vi sinh nở hoa).
Đặc điểm nhận dạng
Hiện tượng vi sinh nở hoa sẽ khiến nước trong bể cá của bạn chuyển sang màu trắng đục như nước vo gạo trong một vài ngày sau đó, do bạn có thay nước cũng không thể cải thiện được hiện tượng này quá nhiều. Độ trong của nước giảm đi đáng kể, nhưng không thể nhìn thấy các hạt nổi bằng mắt thường.

Tác hại của vi sinh nở hoa
- Giảm lượng oxy hòa tan trong nước, khiến các sinh vật thủy sinh bị chết.
- Làm nước đục, khó nhìn.
- Tăng nguy cơ ô nhiễm nước.
- Làm cho nước có mùi hôi khó chịu.
- Gây bệnh cho cá và các sinh vật khác trong bể.
Các yếu tố gây ra bùng vi sinh
Bổ sung quá nhiều dinh dưỡng cho nước
Dinh dưỡng là một yếu tố quan trọng cho sự phát triển của vi khuẩn. Khi có quá nhiều dinh dưỡng trong nước, vi khuẩn sẽ phát triển nhanh chóng và gây ra bacteria bloom. Các nguồn dinh dưỡng có thể đến từ nhiều nguồn, bao gồm:
- Phân cá, thức ăn dư thừa, mùn bã hữu cơ.
- Phân nước hữu cơ

Thay đổi nhiệt độ và pH của nước
Nhiệt độ và pH của nước cũng ảnh hưởng đến sự phát triển của vi khuẩn. Vi khuẩn thường phát triển mạnh trong môi trường nước ấm và có pH trung tính. Khi nhiệt độ và pH của nước thay đổi đột ngột, vi khuẩn sẽ phát triển nhanh chóng và gây ra bacteria bloom.
Thay đổi số lượng cá
Việc tăng giảm số lượng cá cũng là một phần ảnh hưởng tới yếu tố gây ra hiện tượng vi sinh nở hoa mà có thể bạn chưa biết. Số lượng cá tăng lên đồng nghĩa với lượng phân cá và mùn bã hữu cơ trong nước tăng lên.
Các xử lý vi sinh nở hoa
Mặc dù hiện tượng này có thể kéo dài vài ngày cho đến cả tuần, nhưng chúng ta cũng có thể xử lý hiện tượng vi sinh nở hoa hiệu quả và đơn giản bằng vài phương pháp sau:
Thay nước
Thay nước là phương pháp hiệu quả giúp loại bỏ lượng vi sinh trong nước cũng như giảm lượng chất dinh dưỡng dư thừa, điều này sẽ giúp hiện tượng này được cải thiện.

Duy trì nhiệt độ và pH ổn định
Việc duy trì nhiệt độ và pH ổn định sẽ giúp bể thủy sinh của bạn sớm quay lại được sự cân bằng cần thiết để duy trì bể thủy sinh vận hành hoàn hảo.
Kiểm soát lượng cá và lượng dinh dưỡng
Vì hiện tượng vi sinh nở hoa thường do lượng dinh dưỡng trong nước, vậy nên việc kiểm soát lại lượng cá, thức ăn, dinh dưỡng trong bể là yếu tố quan trọng nhất giúp bể của bạn sớm cân bằng.
Sử dụng sản phẩm làm trong nước
Nếu thời gian chờ đợi nước bể cá trong là quá lâu theo các cách trên, hãy tham khảo các sản phẩm làm trong nước giúp bạn xử lý vấn đề đục nước này nhanh chóng. Mình khuyên các bạn nên dùng Biozym Quality Purifier, sản phẩm này sẽ cải thiện rất nhanh hiện tượng đục này chỉ sau 1 tiếng sử dụng.

Bạn có thể tham khảo sản phẩm này: Tại Đây
Các loại vi sinh nở hoa
Có nhiều loại bacteria bloom khác nhau, nhưng phổ biến nhất là:
- Cyanobacteria bloom (nở hoa tảo lam)
- Chlorobacteria bloom (nở hoa vi khuẩn lục)
- Diatom bloom (nở hoa sinh vật phù du)










